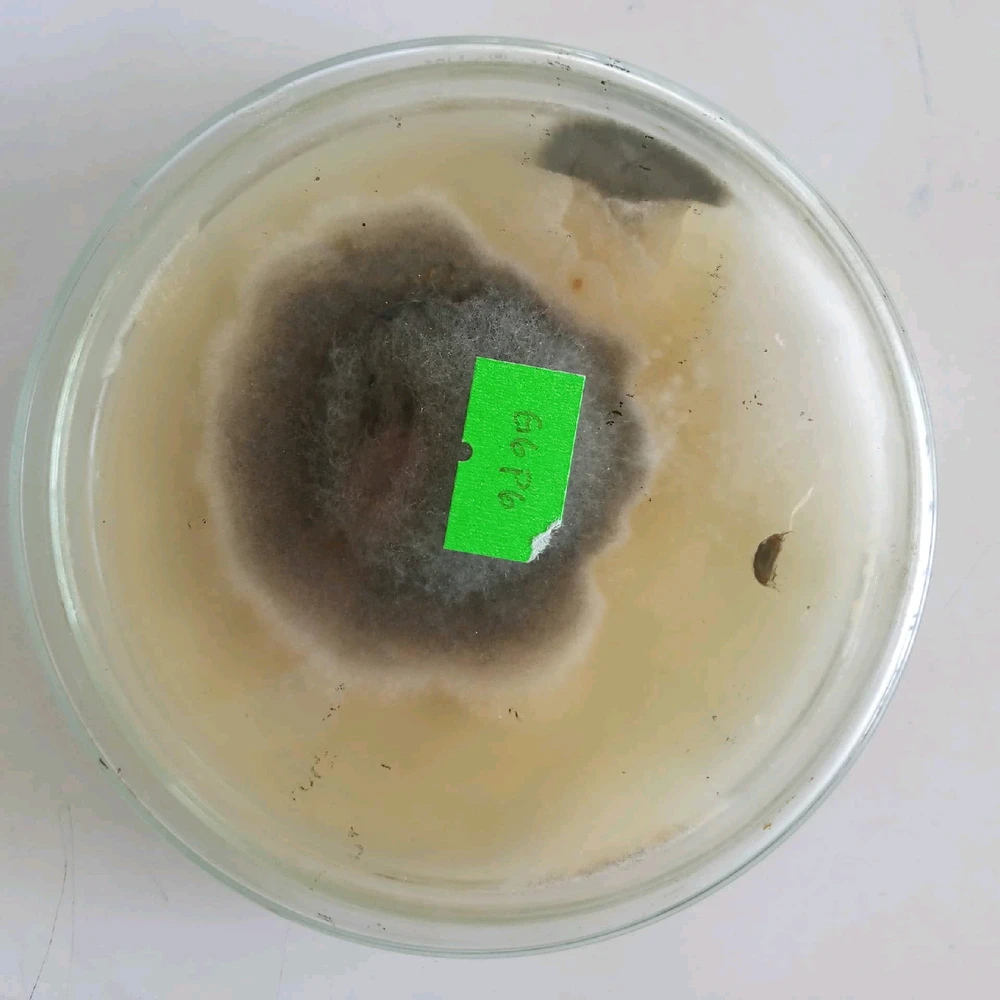
Image uploaded by Frances
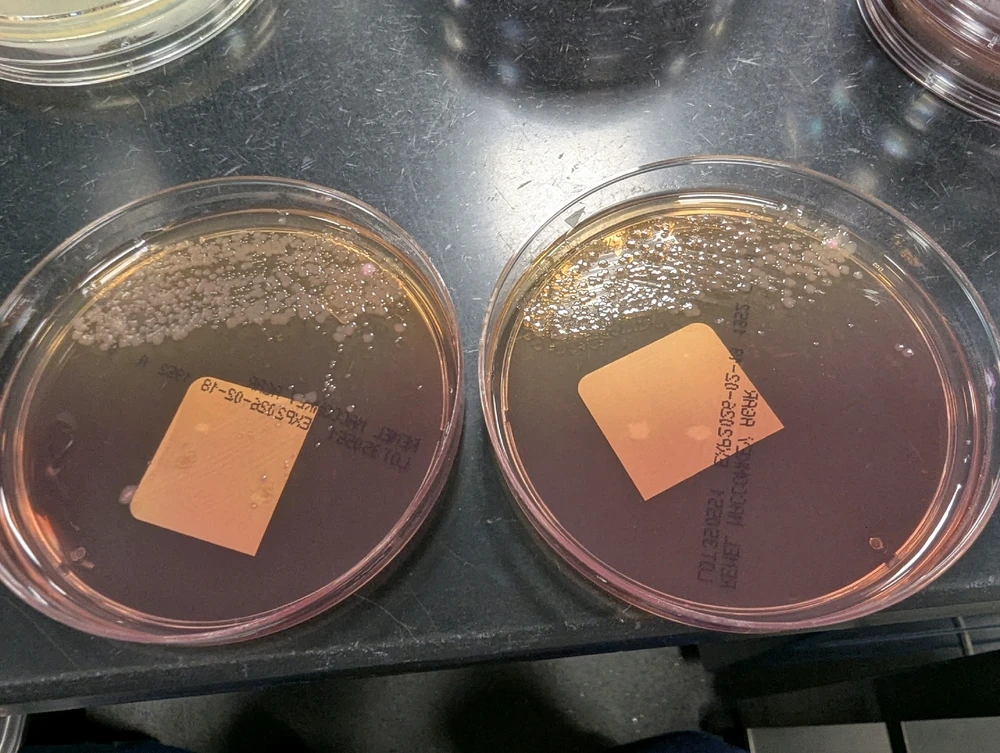

Microbiology Community
The microbiology community, chat, and discussion.
491 souls
491 souls
2y
INFJ
Leo
Cute little croissant shaped fungi

16
3
2y
ENFJ
Libra
Try to guess,what it's?

8
4
1y
INFJ
Scorpio
Winogradsky Column
Estero del Soldado ecosistema Day 0
4
1
3y
ISTJ
Virgo
Microscopic Picture of Volvox.

5
0
2y
INTP
Aries
What's this creepy lizard like creature do I have here? (edited)
4
0
2y
INTJ
Pisces
Prettiest Aspergillus species
4
1
Meet New People
50,000,000+
DOWNLOADS